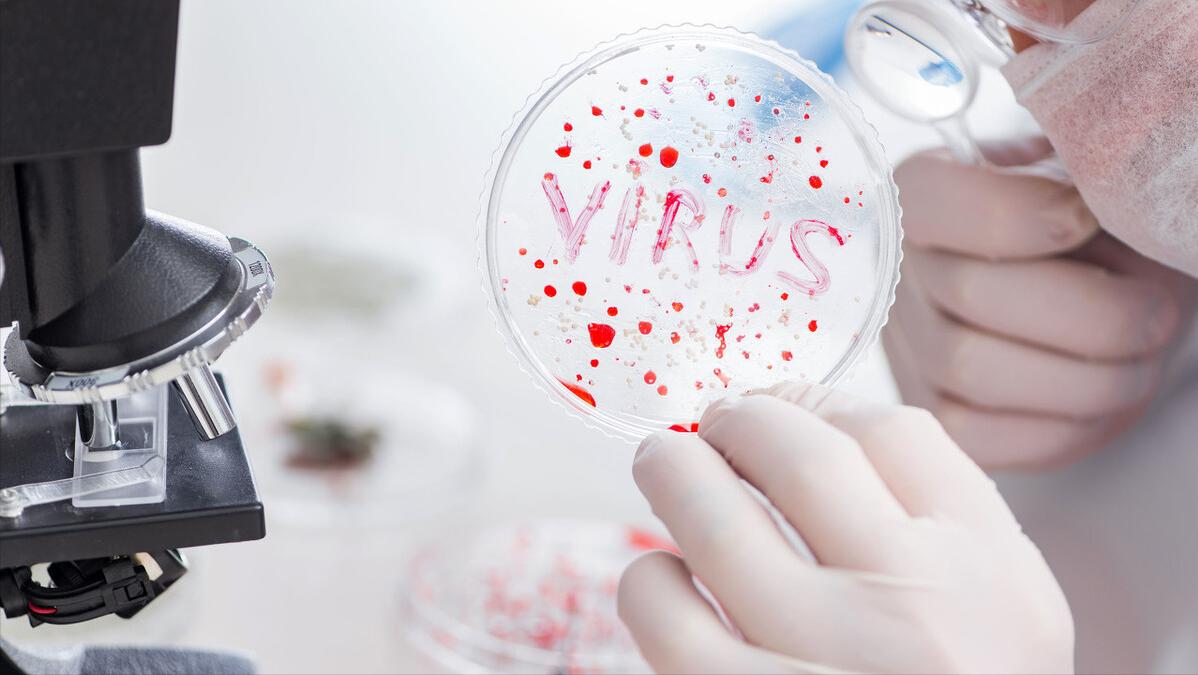
女性屁股中间为啥也会长毛？能不能直接剃掉？医生劝你手下留情

人的身体上有很多的毛发,例如头发、汗毛、腋毛等,这些毛发的存在对皮肤有一定的保护效果。由于每个人的身体情况不同,所以有的人毛发旺盛、有的则毛发稀疏,这都属于正常现象。
但是,最近北京的周女士却因为自己的毛发旺盛发了愁。
近期,周女士在和朋友去澡堂洗澡的时候,被朋友惊讶的问道:“小周,你屁股中间怎么有毛啊,而且毛还这么多。”
周女士觉得有点莫名其妙,自己从小到大屁股中间都是有毛的啊,从来没觉得奇怪,难道其他人没有吗?

周女士定睛一看,果然,她朋友的屁股中间是没有毛的,包括澡堂的其他女生,也没有。
这让周女士有点尴尬,她问道:“这很奇怪吗,我从小就有,以为这是正常的。”
朋友称:“奇不奇怪我不知道,但是我没见过身边其他女性屁股中间长毛的。建议你还是去医院看看,说不定这是不正常的现象。”
故事说到这里,大家可能也和周女士一样产生了疑惑。接下来,就为大家统一解释一下女性屁股中间毛太多是否正常。

一、女性屁股中间毛太多,正常吗?
女性屁股中间毛太多是否正常,这个问题不能一概而论,原因有多种。
首先,可能是正常的生理现象。人体是有很多毛发的,屁股中间的毛也称为肛毛,它和腋毛、头发一样,都属于正常的体毛。这些毛发的产生是因为皮表存在毛囊,随着体内雄性激素的分泌而生长出毛发。由于屁股中间也存在毛囊,所以长出毛发属于正常现象。
如果体内雄性激素分泌较为旺盛,则毛发也会比较茂密。例如男性体内雄性激素分泌的比女性体内多,因此男性体毛普遍较旺盛,这属于正常现象。

但是,屁股中间长出毛发也可能是疾病因素造成,例如患有多毛症。
如果女性患有先天性肾上腺增生症或是先天性卵巢发育不良等,都可能诱发多毛症。若是患有先天性肾上腺增生症,患者体内缺乏21-羟化酶,会导致机体内皮质醇合成量减少,加快促肾上腺皮质激素的分泌,从而造成雄激素分泌量增加,诱发多毛症。
若是患者先天性卵巢发育不良,这属于先天性染色体异常。卵巢属于女性性腺,主要作用为:分泌雌激素、孕酮。当女性先天性卵巢发育不良时,内分泌功能也会受到影响,导致雌激素分泌不足、雄激素过多,从而引发多毛症。

这两种激素因素都可能导致女性屁股中间长毛,患有先天性肾上腺增生症的女性可能因为体内雄激素旺盛而出现阴蒂肥大的症状;先天性卵巢发育不良的女性可能因为内分泌异常出现第二性征不发育、个子矮等症状。
此外,如果女性近期过量使用含有雄激素的药物,例如丙酸*丸睾**酮、*丸睾**片等,都可能导致内分泌紊乱,使体内雄激素含量过高,造成毛发旺盛、屁股中间长毛等症状。
因此,具体导致屁股中间长毛的原因,还是要结合自身情况来看,判断是否合并存在上述疾病症状。

如果核实是生理性原因导致的屁股中间长毛,则无需担心,这不会对身体健康造成负面的影响,并且还有益于人体健康。
毛发生长于皮表,主要作用在于:保护皮肤、调节体温等。
屁股中间长毛,既可以通过遮挡、阻碍的方式防止细菌通过毛囊进入体内,降低皮肤病的患病几率;还能在皮肤受到外界刺激时减少外界物质对皮表的刺激、摩擦,从而保护皮肤健康,缓解皮表疼痛不适感。
并且,毛发属于体内外疏通的一种渠道。天热时,毛发的存在可以促进汗液排出,通过汗液将体内毒素排出体外,还能将体内多余热量排出去,达到散热、调节体温的效果。天冷时,毛发还能起到保暖、御寒的作用。
讲了这么多毛发的好处,可能还是有些爱美的女士想为了美观将屁股中间的毛剃掉。那么,屁股中间的毛能不能直接剃掉呢?

二、屁股中间的毛能不能直接剃掉?医生劝你手下留情
一般情况下,不建议将屁股中间的毛剃掉。
因为很多人在剃毛的时候,手法是不专业的,例如直接用刮胡刀将毛发剃掉。首先,屁股中间的皮肤较为脆弱,如果剃毛的过程中不小心将皮肤刮伤,容易使细菌通过伤口进入体内,导致患处皮肤感染。
有些人还可能通过拔毛的方式将屁股中间的毛拔掉,这属于更错误的方式。因为在拔毛的过程中,会对局部毛囊造成刺激,不仅会产生疼痛感,还可能导致毛囊发炎,出现局部红肿、瘙痒等症状。

其次,毛发本身对皮肤有保护效果,如果将局部毛发剃掉,则皮肤少了一层保护膜,这对脆弱的臀部皮肤来说无异于雪上加霜。
“光秃秃”的皮肤在之前几十年都有毛发的保护,突然少了一层保护后,频繁受到衣物、汗液等物质的摩擦、刺激,很容易引发皮肤问题,例如毛囊炎。
因此,若是生理原因导致的屁股中间长毛,医生一般不建议将毛发剃掉。若是实在想剃掉,需通过卫生、健康、正规的方式,例如至医院进行激光脱毛等。

如果是因为内分泌紊乱或是患有多毛症而导致屁股中间长毛,也不建议剃毛,而是遵医嘱针对病因进行对应治疗。例如内分泌紊乱的患者可以遵医嘱使用调节激素类的药物进行治疗。病因治愈后,屁股中间长毛的症状也会随之缓解。
综上所述,建议女性们接受自己的全貌,每个人都是独一无二的,不要因为毛发的问题而产生自卑心理,要善待且保护好自己的身体。
不剃毛可以从一定程度上保护肛周皮肤的健康,但是并非全面守护。若想保护屏障牢固,日常做好肛门周围的卫生护理也是至关重要的。

三、建议:这样保护肛门卫生
肛门如何保持卫生,主要在于日常的养护。
首先,由于肛门周围皮肤较为脆弱且四周神经密集,所以在清洁局部皮肤时要保持水温适宜,建议水温选择37℃左右,接近人体体温,更容易被皮肤接受。
如果水温过高,可能烫伤表皮层,出现皮肤红肿、疼痛等症状;若是水温过低,不利于女性生殖系统健康,受寒气刺激后可能影响月经稳定,还易出现腹泻、腹痛等症状。

因此,建议温水清洗,清洁臀部后保持肛门周围皮肤的干燥,及时擦干。若是局部长期保持潮湿状态,可能使皮肤屏障功能受损,容易导致真菌生长、螨虫滋生,不仅皮肤感染的几率会随之增大,还易患上湿疹,出现皮肤瘙痒、起丘疹等症状。
其次,清洁肛周皮肤时要选用合适的清洗方式。一般情况下,建议使用流动的水清洗,减少细菌残留。如果条件不允许,建议用专门的盆清洗屁股,不要与其他用途的盆混用,防止病菌交叉感染。

另外,清洁肛周皮肤不宜过度,一般一天清洁一次即可。若是清洗过于频繁,可能影响肛周皮肤的菌群平衡,使皮肤抵抗力下降。无治疗目的的情况下,用清水清洗即可,不建议用市面上贩卖的某些专用洗屁股洗涤剂进行清洗,过度清洗可能影响皮表的酸碱平衡,反而容易引发肛周疾病。
此外,平时要保持规律的排便习惯。建议定时排便,每次排便时间不宜过长,五分钟左右即可,长时间排便不仅会刺激肛门,还易诱发痔疮等肛门疾病。
建议平时采用上述卫生、正确的清洗方式,不仅能保护肛周皮肤健康,还能降低肛门疾病的发病率。

写在最后
屁股中间长毛属于正常的现象,可能是因为自己体内雄激素分泌较为旺盛所致,女性朋友们无需因此感到自卑,要做到“爱自己、保护自己,不因为莫须有的不同而羞愧”。
但是,如果自己身体还出现了其他异常症状,例如身高过度矮小、第二性征不发育等,则要考虑是否是疾病因素诱发的多毛症。这种情况下,建议及时至医院就诊。
参考文献
【1】朱海琴,范卫新.雄激素和毛发生长[J].中国麻风皮肤病杂志,2007(02):149-152.
【2】曾子珣,汤諹. 新型外科治疗女性毛发疾病[C]//全国中西医结合皮肤性病学术会议论文汇编.2023:45.
【3】赵恒光. 毛发疾病的物理治疗[C]//中国中西医结合学会汇编2023:37.